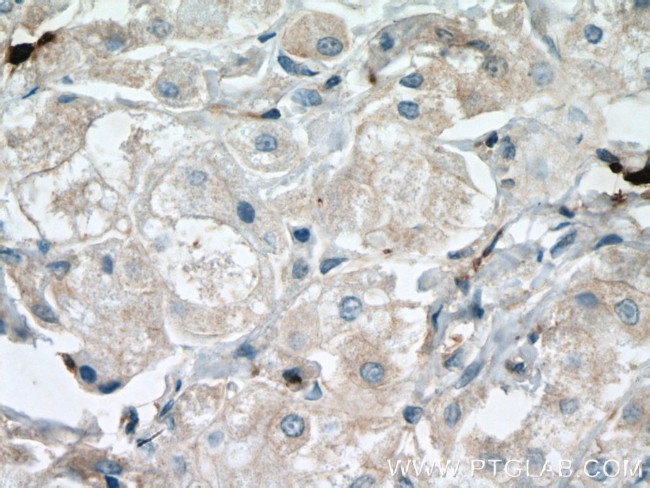
FBP17 Antibody in Immunohistochemistry (Paraffin) (IHC (P))

Search
Proteintech
FBP17 Polyclonal Antibody
{{$productOrderCtrl.translations['antibody.pdp.commerceCard.promotion.promotions']}}
{{$productOrderCtrl.translations['antibody.pdp.commerceCard.promotion.viewpromo']}}
{{$productOrderCtrl.translations['antibody.pdp.commerceCard.promotion.promocode']}}: {{promo.promoCode}} {{promo.promoTitle}} {{promo.promoDescription}}. {{$productOrderCtrl.translations['antibody.pdp.commerceCard.promotion.learnmore']}}
产品信息
27056-1-AP
种属反应
宿主/亚型
分类
类型
抗原
偶联物
形式
浓度
规格
纯化类型
保存液
内含物
保存条件
运输条件
产品详细信息
Immunogen sequence: AQIRHQMAE DSKADYSSIL QKFNHEQHEY YHTHIPNIFQ KIQEMEERRI VRMGESMKTY AEVDRQV (176-241 aa encoded by BC101755 )
靶标信息
The protein encoded by this gene is a member of the formin-binding-protein family. The protein contains an N-terminal Fer/Cdc42-interacting protein 4 (CIP4) homology (FCH) domain followed by a coiled-coil domain, a proline-rich motif, a second coiled-coil domain, a Rho family protein-binding domain (RBD), and a C-terminal SH3 domain. This protein binds sorting nexin 2 (SNX2), tankyrase (TNKS), and dynamin; an interaction between this protein and formin has not been demonstrated yet in human.
仅用于科研。不用于诊断过程。未经明确授权不得转售。
篇参考文献 (0)
生物信息学
蛋白别名: formin binding protein 17; Formin-binding protein 1; Formin-binding protein 17; hFBP17; MGC126804; unnamed protein product
基因别名: 1110057E06Rik; 2210010H06Rik; FBP1; FBP17; FNBP1; KIAA0554
UniProt ID: (Human) Q96RU3, (Mouse) Q80TY0
Entrez Gene ID: (Human) 23048, (Mouse) 14269